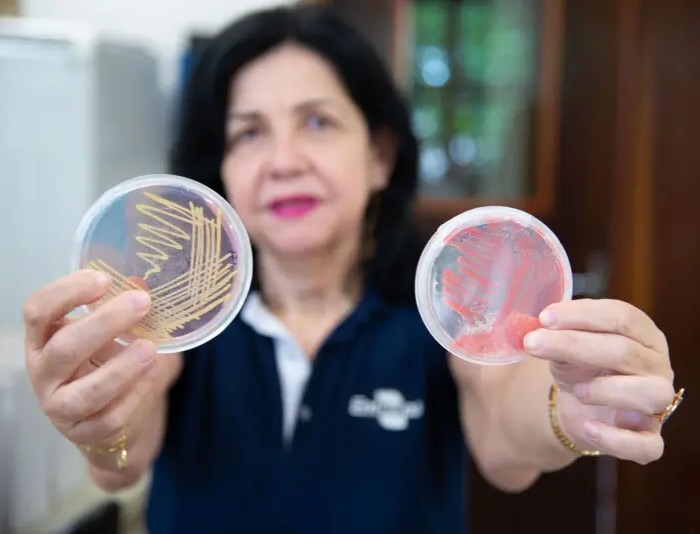

Atualizado 28 de fevereiro de 2026
Pesquisadora da Embrapa no Brasil recebeu “Nobel de Agricultura” por desenvolver alternativa sustentáveis com microrganismos em sementes para substituir insumos químicos.
A Cientista Mariangela Hungria foi laureada da edição de 2025 do Prêmio Mundial de Alimentação – World Food Prize (WFP).
O anuncio da Laurea foi no dia 13 de maio de 2025, e a premiação recebida em outubro: “Scientist Whose Biological Seed Treatments Helped Make Brazil A Global Breadbasket Named 2025 World Food Prize Laureate“.
Entre na Seleção Nature & Space
Inscreva-se Grátis e Receba Nosso Kit Exclusivo:
1. E-Book: "Astrobiologia e as Origens da Vida no Universo"
2. Acesso à Nature & Space TV
3. Radar Semanal
Foi uma vida dedicada à busca por altos rendimentos, mas via uso de biológicos, substituindo parcial ou totalmente os fertilizantes químicos.
Há mais de três décadas, a Cientista Mariangela Hungria pesquisa formas de substituir fertilizantes químicos por alternativas sustentáveis, como os inoculantes, produtos com microrganismos benéficos que ajudam as plantas a absorver nutrientes.
A Pesquisadora também foi Pesquisadora foi agraciada com o Prêmio Mulheres e Ciência, parceria entre o MCTI, CNPq, Ministério das Mulheres, British Council e CAF.
Veremos a seguir como a cientista Mariangela Hungria desenvolveu sua abordagem revolucionária a partir de uso de microrganismos para substituir insumo químico. Em texto, imagens e vídeos.
Quais a vantagens de usar microrganismos nas lavouras? Seria possível promover uma transição para agriculturas ecológicas? Você Conhece a Agroecologia e outras alternativas de agriculturas ecológicas? Deixe seu comentário no final!
Vídeo 1: Prêmio Mundial da Alimentação 2025 Mariangela Hungria
Vídeo 2: Pesquisadora brasileira ganha prêmio ‘Nobel’ da Agricultura
▶️Clique e SIGA Nature & Space no YouTube: Explore PlayLists Relacionadas ao Site!
LEIA MAIS
Índice Calcula Tempo de Vida Ganho ou Perdido com Alimento | Nature & Space
Proteína Vegetal Aumenta Expectativa de Vida em Adultos | Nature & Space
Substituto Promissor: Plástico de Celulose de Bactérias | Nature & Space
Compartilhar é Livre. Ajude-nos Citando o Link Deste Artigo!
Mariangela Hungria, microbiologista brasileira, passou 4 décadas procurando bactérias no solo que agiriam como fertilizante, aumentando as colheitas e reduzindo fertilizantes químicos
A cientista brasileira Mariangela Hungria, pesquisadora da Embrapa Soja e membro titular da e integrante da diretoria da Academia Brasileira de Ciências, foi laureada com o Prêmio Mundial de Alimentação (World Food Prize), reconhecido como o “Nobel” da agricultura.
O Prêmio da Fundação World Food Prize – WFP é Concedido anualmente. O prêmio reconhece as personalidades que contribuem para aprimorar a qualidade e disponibilidade de alimentos no mundo.
Mariangela Hungria, uma microbiologista brasileira, passou décadas procurando bactérias no solo que pudessem agir como fertilizante, aumentando as colheitas dos agricultores. Mas ela enfrentou muito ceticismo.

“Quando comecei minha carreira, todo mundo dizia: ‘Você é louca! Você nunca vai conseguir. Isso nunca será possível'”, ela relembra.
A fundação World Food Prize destacou que as descobertas de Mariângela ajudaram o Brasil a se tornar uma potência agrícola global.
Com mais de 40 anos dedicados a pesquisas, Mariangela é reconhecida pelo desenvolvimento de tecnologias inovadoras em microbiologia do solo.
“Substituir o uso de produtos químicos por produtos biológicos na agricultura tem sido a luta da minha vida. Tenho muito orgulho de contribuir para a produção de alimentos e, ao mesmo tempo, diminuir o impacto ambiental.
A meta era aumentar a produtividade com o menor uso possível de produtos químicos, e conseguimos isso com mais produtos biológicos”, afirmou Mariangela

Inspirada por Johanna Döbereiner, reconhecida internacionalmente por suas contribuições à agricultura, Mariangela foi uma das primeiras defensoras da fixação biológica de nitrogênio, processo no qual culturas formam uma associação mutuamente benéfica com as bactérias do solo que fornecem nitrogênio, nutriente essencial para o crescimento das plantas.
Para ela, a láurea é um reconhecimento também à ciência feita no Brasil e um estímulo a outras pesquisadoras.
“Não consigo acreditar que agora estou recebendo o Prêmio Mundial da Alimentação. Muitas pessoas questionaram minha capacidade ao longo de minha carreira, mas eu acreditei no que estava fazendo e perseverei.
O papel das mulheres na agricultura, da agricultura à ciência, merece mais reconhecimento. Espero que minha conquista inspire outras pessoas a perseguirem suas paixões na ciência.”
▶️Clique e SIGA Nature & Space no YouTube: Explore PlayLists Relacionadas ao Site!
Vídeo 1: Prêmio Mundial da Alimentação 2025 Mariangela Hungria
LEIA MAIS
Teste Reduziu Idade Biológica 15 Anos ao Retirar 3 Alimentos | Nature & Space
Carne Cultivada de Célula Animal Com Proteína Vegetal | Nature & Space
Clonada Araucária Vigorosa de 700 Anos para Reflorestar
Compartilhar é Livre. Ajude-nos Citando o Link Deste Artigo!
Amantes do Cosmos e da Terra
Apoie a Continuidade da Nature & Space Doando Qualquer Valor.
Pesquisas dedicadas a produção e qualidade alimentar por meio da substituição total ou parcial de fertilizantes químicos por microrganismos
Ao longo da carreira, desenvolveu dezenas de tratamentos biológicos, reduzindo a necessidade de fertilizantes sintéticos e aumentando a produtividade.
A estimativa é que suas tecnologias tenham sido usadas em mais de 40 milhões de hectares no Brasil, economizando aos agricultores até US$ 25 bilhões por ano em custos de insumos e evitando mais de 230 milhões de toneladas de emissões equivalentes de CO2 por ano.

Segundo a Embrapa, onde atua desde 1982, a ênfase das pesquisas de Mariangela tem sido no aumento da produção e na qualidade de alimentos por meio da substituição total ou parcial de fertilizantes químicos por microrganismos portadores de propriedades como fixação biológica de nitrogênio, síntese de fitormônios e solubilização de fosfatos e rochas potássicas.
A ênfase das suas pesquisas tem sido no aumento da produção e na qualidade de alimentos por meio da substituição total ou parcial de fertilizantes químicos por microrganismos portadores de propriedades como fixação biológica de nitrogênio (FBN), síntese de fitormônios e solubilização de fosfatos e rochas potássicas.
Além das pesquisas com soja, Mariangela também já coordenou estudos que levaram a tecnologias para outras culturas, como feijão, milho e trigo.

O uso da inoculação na soja com bactérias fixadoras de nitrogênio (Bradyrhizobium), que pode ser ainda mais benéfico se associado à coinoculação com a bactéria Azospirilum brasiliense.
Somente em 2024, por exemplo, esta tecnologia propiciou uma economia estimada de 25 bilhões de dólares, ao dispensar o uso de adubos nitrogenados.
A pesquisadora estima esse valor considerando a área de soja, a produção de soja, o valor do fertilizante (ureia) que seria necessário para essa produção, e a eficiência de uso do fertilizante nitrogenado.
Além deste benefício, Mariangela explica que essa tecnologia evitou, em 2024, a emissão de mais de 230 milhões de toneladas de CO₂ equivalentes por ano para a atmosfera.
▶️Clique e SIGA Nature & Space no YouTube: Explore PlayLists Relacionadas ao Site!
Vídeo 2: Pesquisadora brasileira ganha prêmio ‘Nobel’ da Agricultura
LEIA MAIS
Batata Teve Origem no Cruzamento Entre Tomate e Outra Planta, Há 9 Milhões de Anos | Nature & Space
Antigos Milharais na Bolívia Ajudaram a Domesticar o Pato
Compartilhar é Livre. Ajude-nos Citando o Link Deste Artigo!
Amantes do Cosmos e da Terra
Apoie a Continuidade da Nature & Space Doando Qualquer Valor.
Ela descobriu que algumas cepas de rizóbios na soja a cada ano aumentaria a produtividade em 8 % em comparação com fertilizantes sintéticos
Hoje, a inoculação da soja é adotada anualmente em aproximadamente 85% da área total cultivada de soja, hoje cerca de 40 milhões de hectares — representando a maior taxa de adoção de inoculação do mundo.
Associado aos trabalhos com soja, a pesquisadora também coordena pesquisas que culminaram com o lançamento de outras tecnologias: autorização/recomendação de bactérias (rizóbios) e coinoculação para a cultura do feijoeiro, Azospirillum brasiliense para as culturas do milho e do trigo e de pastagens com braquiárias.

Ainda em relação às gramíneas, em 2021, a equipe da pesquisadora lançou uma tecnologia que permite a redução de 25% na fertilização nitrogenada de cobertura em milho por meio da inoculação com A. brasilense, gerando benefícios econômicos significativos para os agricultores e impactos ambientais positivos para o país.
Sob a orientação da Dra. Johanna Döbereiner, a Dra. Hungria foi uma das pioneiras na defesa da fixação biológica de nitrogênio, processo no qual as culturas agrícolas estabelecem uma associação mutuamente benéfica com bactérias do solo, fornecendo nitrogênio, um nutriente essencial para o crescimento das plantas.
No início de sua carreira, havia pouquíssima pesquisa sobre a microbiologia como solução para a fertilidade do solo.
Ela começou estudando rizóbios, um tipo de bactéria que interage com as raízes de plantas leguminosas para fornecer nitrogênio em troca de energia.
Ela descobriu que a aplicação dessa cepa na soja por meio de um inoculante a cada ano poderia aumentar a produtividade em até oito por cento em comparação com o uso de fertilizantes sintéticos.
Ela também foi a primeira a isolar cepas da bactéria Azospirillum brasilense que poderiam melhorar a absorção de nitrogênio e fitormônios.
Sua pesquisa mostrou que a combinação e aplicação de A. brasilense e rizóbios poderia dobrar o aumento da produtividade do feijão comum e da soja.
Hoje, mais de 70 milhões de doses de inoculantes combinados são vendidas e aplicadas em cerca de 15 milhões de hectares no Brasil a cada ano.
▶️Clique e SIGA Nature & Space no YouTube: Explore PlayLists Relacionadas ao Site!
LEIA MAIS
A Enigmática Dispersão das Castanheiras na Amazônia
Brasil: Mapa Revela Má Alimentação e Ultraprocessados
Compartilhar é Livre. Ajude-nos Citando o Link Deste Artigo!
Amantes do Cosmos e da Terra
Apoie a Continuidade da Nature & Space Doando Qualquer Valor.
Ela desenvolveu o primeiro inoculante para recuperação de pastagens degradadas, aumentando em 22% na biomassa e melhor alimento para o gado
A Dra. Hungria, professora da Universidade Estadual do Paraná e da Universidade Tecnológica Federal do Paraná, está aplicando suas pesquisas na recuperação de pastagens degradadas.
Ela desenvolveu o primeiro inoculante para pastagens, resultando em um aumento de 22% na biomassa, o que proporciona mais e melhor alimento para o gado.

“Quando comecei, ninguém falava sobre fixação biológica de nitrogênio. Mas eu adorava microbiologia, adorava ciência básica e tinha muitas ideias que queria investigar e estudar”, disse a Dra. Hungria.
“Substituir o uso de produtos químicos por produtos biológicos na agricultura tem sido a luta da minha vida. Tenho muito orgulho de contribuir para a produção de alimentos e,
ao mesmo tempo, diminuir o impacto ambiental. O objetivo era aumentar a produtividade com o mínimo possível de produtos químicos, e conseguimos isso com o uso mais frequente de produtos biológicos.”
A Dra. Hungria, que superou preconceitos contra mulheres e mães jovens no meio acadêmico para ser nomeada uma das 100 mulheres mais poderosas da agricultura no Brasil pela Forbes em 2021, disse que foi inspirada pelo Dr. Norman Borlaug, pai da Revolução Verde e fundador do Prêmio Mundial da Alimentação.
“Gosto de dizer que ele tornou a Revolução Verde possível, e tivemos essa grande oportunidade de iniciar uma ‘micro revolução verde’ – uma revolução verde, mas com microrganismos”, acrescentou.
“Ainda não consigo acreditar que estou recebendo o Prêmio Mundial da Alimentação. Muitas pessoas questionaram a mim e às minhas capacidades ao longo da minha carreira, mas eu acreditei no que estava fazendo e perseverei.
O papel das mulheres na agricultura, da agricultura à ciência, merece mais reconhecimento. Espero que minha conquista inspire outras pessoas a seguirem suas paixões na ciência.”
Autora de mais de 500 artigos, capítulos e publicações, a Dra. Hungria produziu o primeiro manual em língua portuguesa sobre métodos de microbiologia do solo adaptados aos trópicos.
Ela figura na lista do 1% dos melhores cientistas agrícolas da Universidade Stanford desde 2020 e recebeu a mais alta honraria do Brasil na área agrícola, o Prêmio Frederico de Menezes Veiga.
Conforme Organização do Prêmio Global de Agricultura:
“A Dra. Hungria foi escolhida por suas extraordinárias conquistas científicas na área da fixação biológica de nitrogênio, que transformaram a sustentabilidade da agricultura na América do Sul”, disse a Dra. Gebisa Ejeta, Presidente do Comitê de Seleção do Prêmio Mundial da Alimentação.
“Seu brilhante trabalho científico e sua visão comprometida com o avanço da produção agrícola sustentável para alimentar a humanidade com o uso criterioso de fertilizantes químicos e corretivos biológicos lhe renderam reconhecimento global, tanto em seu país quanto no exterior.”
▶️Clique e SIGA Nature & Space no YouTube: Explore PlayLists Relacionadas ao Site!
Bibliografia
Curadoria Técnica e Análise Audiovisual: Conteúdo Bibliográfico e Audiovisual Selecionado e Validado por Dr. Sergio Almeida Loiola – CV Lattes/CNPq.
Academia Brasileira de Ciências
Mariangela Hungria ganha o “Nobel” da agricultura mundial
Prêmio Mundial de Alimentação – World Food Prize (WFP)
Embrapa
Governo Federal do Brasil
Mariangela Hungria é a primeira brasileira a receber o prêmio Nobel da Agricultura
G1
Pesquisadora brasileira ganha prêmio considerado ‘Nobel da Agricultura’
BBC
NPR ORG
The “Oscar” of culinary awards went to a Brazilian who knew how to harness the power of bacteria.
Análise Audiovisual
Vídeo 1-Soja Radar da Tecnologia: Prêmio Mundial da Alimentação 2025 Mariangela Hungria
Vídeo 2- Globo Rural: Pesquisadora brasileira ganha prêmio ‘Nobel’ da Agricultura
Política de Uso
Compartilhar é Livre. Ajude-nos Citando o Link Deste Artigo!













